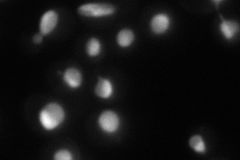
YNL186W
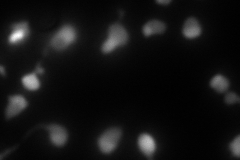
YNL186W
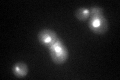
YNL186W
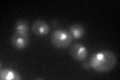
YNL186W

View description
Ubiquitin-specific protease that deubiquitinates ubiquitin-protein moieties; may regulate silencing by acting on Sir4p; involved in posttranscriptionally regulating Gap1p and possibly other transporters; primarily located in the nucleus
Localization:
Intensity:
Fold change:
Significance:
-
C’ GFP library in SD

nucleus64.21 -
N' NOP1pr-GFP in SD
nucleolus99.3069 -
N' TEF2pr-mCherry in SD
nucleus,nucleolus93.1116 -
N' NATIVEpr-GFP in SD

nucleus,nucleolus30.5717 -
N' TEF2pr-VC and Cyto-VN in SD

nucleus,nucleolus46.6728 -
C’ GFP library in SD+DTT
nucleus43.620.67No -
C’ GFP library in SD+H2O2
nucleus56.20.87No -
C’ GFP library in Starvation Media

nucleus33.440.52Yes -
C’ GFP library on the background of Pup2-DaMP

punctate -
C’ GFP library on the background of CCT mutant

nucleus73.94561.15139No
